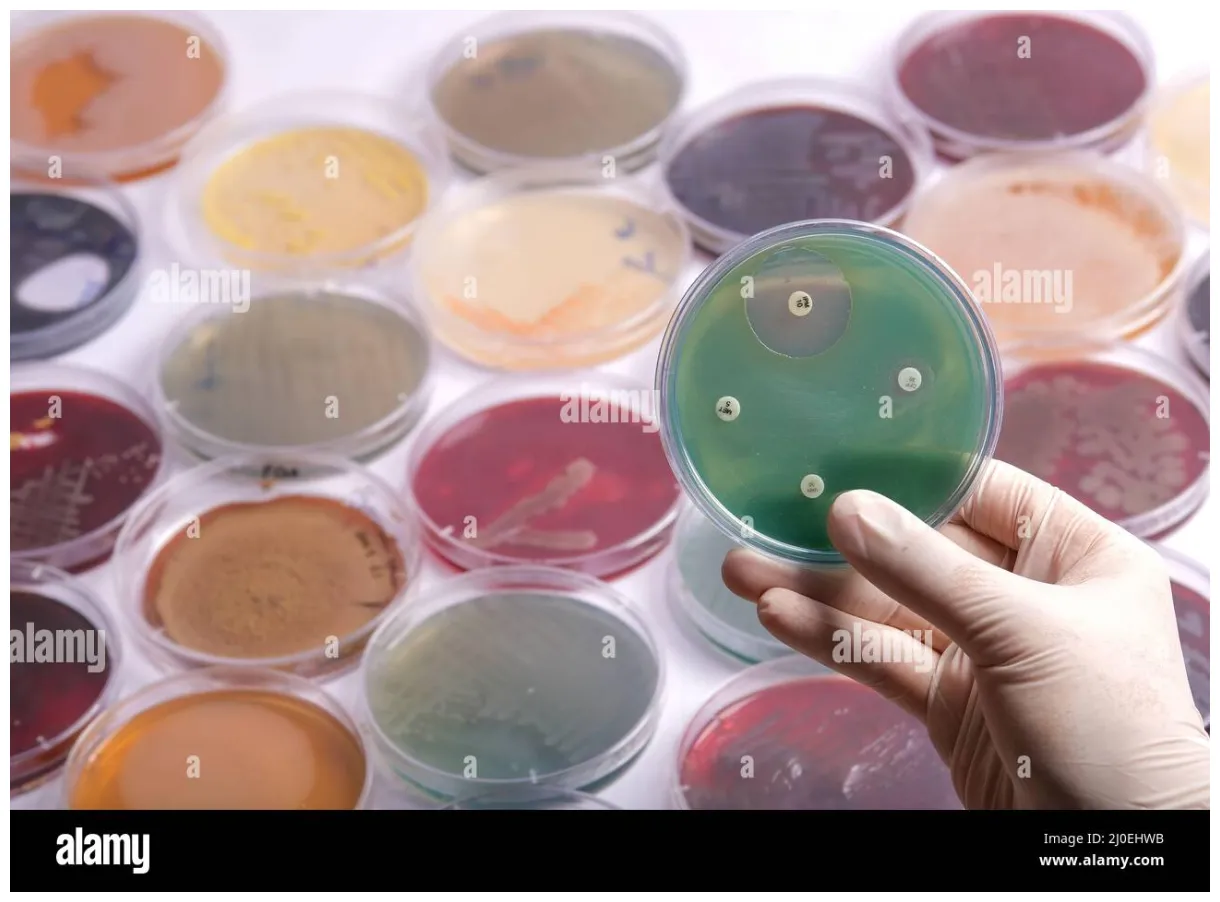
la collecte de plaques de culture contient la croissance de micro

Zonage permaculture autosuffisance Europe - Idées (Gratuit)
La meilleure collection de Zonage permaculture autosuffisance Europe Idées et inspiration pour Zonage permaculture autosuffisance Europe . Téléchargez ces images gratuitement.
Idées et inspiration pour Système de culture surface 40m2 collection. Téléchargez ces images gratuitement.

Commentaires
Enregistrer un commentaire